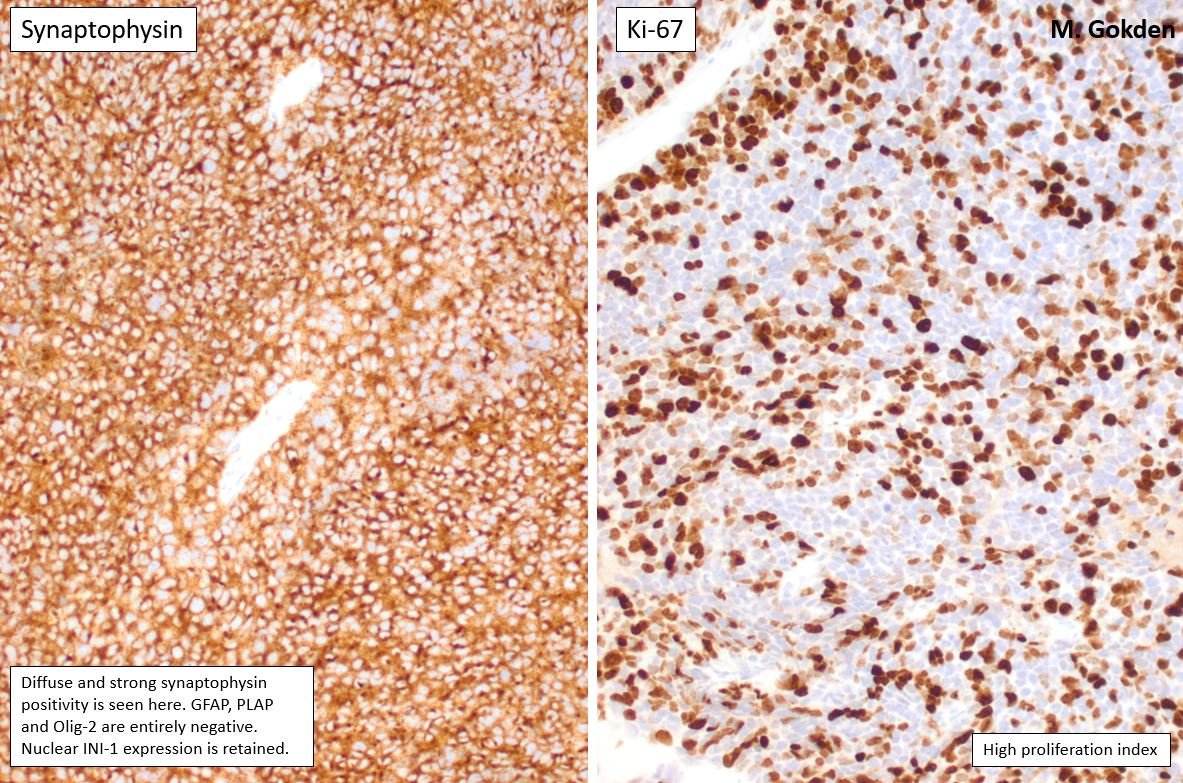
AANP tweet media

@CraigHorbinski @NeuroOnc @BrainTumorInst @NeurosurgeryNM @NU_Pathology @TheUSCAP @LurieCancer @neuropathology Good news for that patient! It may be that some or all of these types cases behave like PXA, but my point is that there is not yet a published study which shows that definitively.
English